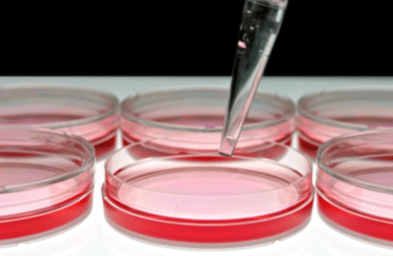

We live in an age where food is grossly abundant. Those distant days when people foraged the land for plants to eat — and even when they shifted to setting up their own farms — seems almost inconceivable now. The intensive nature of the food industry has meant that there’s virtually nothing you can’t buy on a trip to your local supermarket, even if it’s come from the other side of the world.
We live in an age where food is grossly abundant. Those distant days when people foraged the land for plants to eat — and even when they shifted to setting up their own farms — seems almost inconceivable now. The intensive nature of the food industry has meant that there’s virtually nothing you can’t buy on a trip to your local supermarket, even if it’s come from the other side of the world.
But food production on such a humongous scale has come at a fatal price for the planet, and we’re beginning to realise that alternatives to mass farming are needed if there’s any hope of turning things around.
Enter lab-grown meat also known as ‘clean meat’ — the usual deal to what we’re currently eating by all intents and purposes, but with a major difference: it doesn’t involve rearing or killing any animals. And that means significantly fewer CO2 emissions, less animal suffering, more available land and reduced impact on the environment.
Enter lab-grown meat also known as ‘clean meat’ — the usual deal to what we’re currently eating by all intents and purposes, but with a major difference: it doesn’t involve rearing or killing any animals. And that means significantly fewer CO2 emissions, less animal suffering, more available land and reduced impact on the environment.
In a nutshell, stem cells taken from the tissue of livestock animals, such as cows and pigs, are cultured in the lab and grown into muscle tissue, which can then be used to make our favourite meaty goods including burgers — 80,000 of them from a single tissue sample in fact, according to lab meat start-up Mosa Meat. The cells are treated much like those in a usual research lab, being incubated with heat and fed nutrients like salts and sugars to help them multiply and differentiate.
They might not taste quite like the real deal though. Due to a lower fat content, early versions of lab-grown meat were much drier and denser than what we’re usually used to. Plus, the price tag associated with a single patty — $30,000 in 2013 — means there’s still a way to go in achieving the perfect cultured burger. Although there have been drastic improvements to both the flavour and price since, the cost of the growth molecules vital for the culturing process (often proteins in the form of serum from animal blood) still makes it difficult to match the price of a normal supermarket burger. It’s also no mean feat to simply grow meat in the first place, requiring a substantial amount of time, effort and — ultimately — yet more money.
 And whether people would take to their food coming fresh out of a Petri dish in the lab is another matter. With genetically-modified crops still a very current topic of debate and controversy, it’s not unreasonable to assume a similar outcry might occur if lab-grown meat were to make it mainstream. In studies, people’s main worry was how it might harm their health, even though there hasn’t been anything to suggest the lab-grown version is unsafe.
And whether people would take to their food coming fresh out of a Petri dish in the lab is another matter. With genetically-modified crops still a very current topic of debate and controversy, it’s not unreasonable to assume a similar outcry might occur if lab-grown meat were to make it mainstream. In studies, people’s main worry was how it might harm their health, even though there hasn’t been anything to suggest the lab-grown version is unsafe.
At a time when more and more of us are exploring our culinary options and scrutinising current practices, and going veggie or vegan is gaining traction, could lab-grown meat also be making its way into the kitchen and supermarket one day?
About the author:
Gege Li
Twitter handle: @YGegeLi
University affiliation: The University of Sheffield, UK
Graduated in BSc Biochemistry and Microbiology, and MSc Science Communication; currently interning at New Scientist magazine (https://www.newscientist.com/author/gege-li/); aspiring science writer.

